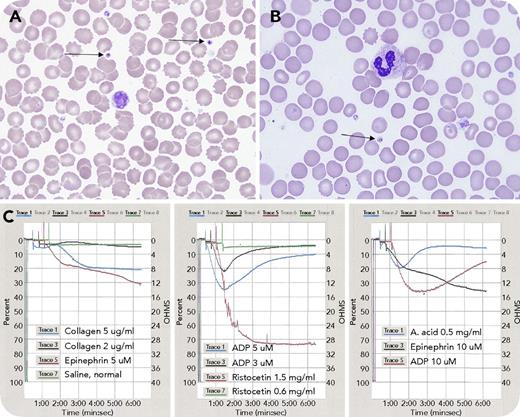
A 3-year-old boy presented with a medical history of facial malformation, single kidney, hypoplastic left ventricle, and complex deletion of chromosome 11 at q24.2q25, consistent with Jacobsen syndrome. He had an International Society on Thrombosis and Haemostasis bleeding assessment tool score of zero, but was thrombocytopenic at birth, with gradual normalization. Laboratory findings were: white blood cell count, 6.8 × 109/L; red blood cell count, 6.45 × 1012/L; hemoglobin, 16.2 g/dL; hematocrit, 48.8%; mean corpuscular volume, 75.7 fL; platelets, 115 × 109/L; prothrombin time, 12.6 seconds; international normalized ratio, 0.93; and activated partial thromboplastin time, 26.2 seconds. Peripheral blood smear showed variation in platelet morphology, with occasional giant forms and large granules, including large solitary inclusions in 8% of platelets (panels A-B, arrows; original magnification ×1000; Wright-Giemsa stain), consistent with α-granule fusion. Light transmission platelet aggregometry revealed abnormal responses to adenosine 5′-diphosphate and arachidonic acid: initial aggregation followed by complete disaggregation; epinephrine: biphasic pattern with delayed and reduced maximum aggregation; and collagen: no aggregation (panel C). / Differential diagnosis for macrothrombocytopenia is broad. Considering the patient’s known Jacobsen syndrome, the qualitative platelet defects are consistent with Paris-Trousseau thrombocytopenia as a result of mutations in FLI1 transcription factor gene involved in megakaryopoiesis. The platelet aggregometry findings suggest a dense granule storage pool deficiency. Supplementary investigations will be necessary to identify whether the granule defects are causative of the platelet dysfunction. Lifestyle modifications and avoidance of platelet-impairing medications are recommended because of potential increased bleeding risk.

A 3-year-old boy presented with a medical history of facial malformation, single kidney, hypoplastic left ventricle, and complex deletion of chromosome 11 at q24.2q25, consistent with Jacobsen syndrome. He had an International Society on Thrombosis and Haemostasis bleeding assessment tool score of zero, but was thrombocytopenic at birth, with gradual normalization. Laboratory findings were: white blood cell count, 6.8 × 109/L; red blood cell count, 6.45 × 1012/L; hemoglobin, 16.2 g/dL; hematocrit, 48.8%; mean corpuscular volume, 75.7 fL; platelets, 115 × 109/L; prothrombin time, 12.6 seconds; international normalized ratio, 0.93; and activated partial thromboplastin time, 26.2 seconds. Peripheral blood smear showed variation in platelet morphology, with occasional giant forms and large granules, including large solitary inclusions in 8% of platelets (panels A-B, arrows; original magnification ×1000; Wright-Giemsa stain), consistent with α-granule fusion. Light transmission platelet aggregometry revealed abnormal responses to adenosine 5′-diphosphate and arachidonic acid: initial aggregation followed by complete disaggregation; epinephrine: biphasic pattern with delayed and reduced maximum aggregation; and collagen: no aggregation (panel C).
Differential diagnosis for macrothrombocytopenia is broad. Considering the patient’s known Jacobsen syndrome, the qualitative platelet defects are consistent with Paris-Trousseau thrombocytopenia as a result of mutations in FLI1 transcription factor gene involved in megakaryopoiesis. The platelet aggregometry findings suggest a dense granule storage pool deficiency. Supplementary investigations will be necessary to identify whether the granule defects are causative of the platelet dysfunction. Lifestyle modifications and avoidance of platelet-impairing medications are recommended because of potential increased bleeding risk.
A 3-year-old boy presented with a medical history of facial malformation, single kidney, hypoplastic left ventricle, and complex deletion of chromosome 11 at q24.2q25, consistent with Jacobsen syndrome. He had an International Society on Thrombosis and Haemostasis bleeding assessment tool score of zero, but was thrombocytopenic at birth, with gradual normalization. Laboratory findings were: white blood cell count, 6.8 × 109/L; red blood cell count, 6.45 × 1012/L; hemoglobin, 16.2 g/dL; hematocrit, 48.8%; mean corpuscular volume, 75.7 fL; platelets, 115 × 109/L; prothrombin time, 12.6 seconds; international normalized ratio, 0.93; and activated partial thromboplastin time, 26.2 seconds. Peripheral blood smear showed variation in platelet morphology, with occasional giant forms and large granules, including large solitary inclusions in 8% of platelets (panels A-B, arrows; original magnification ×1000; Wright-Giemsa stain), consistent with α-granule fusion. Light transmission platelet aggregometry revealed abnormal responses to adenosine 5′-diphosphate and arachidonic acid: initial aggregation followed by complete disaggregation; epinephrine: biphasic pattern with delayed and reduced maximum aggregation; and collagen: no aggregation (panel C).
Differential diagnosis for macrothrombocytopenia is broad. Considering the patient’s known Jacobsen syndrome, the qualitative platelet defects are consistent with Paris-Trousseau thrombocytopenia as a result of mutations in FLI1 transcription factor gene involved in megakaryopoiesis. The platelet aggregometry findings suggest a dense granule storage pool deficiency. Supplementary investigations will be necessary to identify whether the granule defects are causative of the platelet dysfunction. Lifestyle modifications and avoidance of platelet-impairing medications are recommended because of potential increased bleeding risk.
For additional images, visit the ASH Image Bank, a reference and teaching tool that is continually updated with new atlas and case study images. For more information, visit http://imagebank.hematology.org.
This feature is available to Subscribers Only
Sign In or Create an Account Close Modal